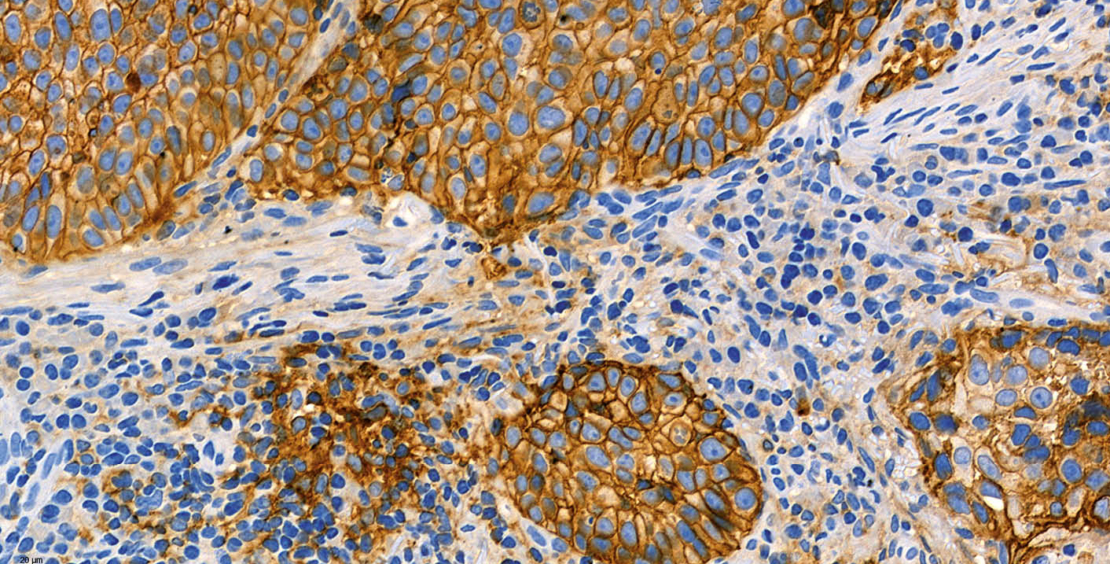

- PD-L1 Status: ein prädiktiver Biomarker in der Onkologie
Immuncheckpunkt-Inhibitoren (ICI) haben sich als wirksame Therapiemodalität bei Tumorerkrankungen etabliert. Am besten ist aktuell der Programmed cell death ligand 1 (PD-L1) Status des Tumors als prädiktiver Biomarker für ein Ansprechen auf PD-1/PD-L1 Inhibitoren validiert. In der Schweiz ist aktuell eine PD-L1 Testung allerdings nur für die Anwendung von Pembrolizumab und Atezolizumab in bestimmten Indikationen erforderlich.
Immuncheckpunkte wirken als Schlüsselregulatoren des Immunsystems. Es handelt sich um Oberflächenrezeptoren auf T-Lymphozyten, die durch spezifische Liganden aktiviert werden und bei Aktivierung die T-Zell-Funktion hemmen oder steigern können. Die Beseitigung einer Checkpunkt-vermittelten Immunhemmung kann als therapeutisches Wirkprinzip bei onkologischen Erkrankungen eingesetzt werden. In der klinischen Anwendung sind aktuell Inhibitoren gegen PD-1, PD-L1 und CTLA-4 (1).
Derzeit sind in der Schweiz sechs Inhibitoren des PD-1/PD-L1 Immuncheckpunkts zugelassen (PD-1 Inhibitoren: Nivolumab, Pembrolizumab, Cemiplimab; PD-L1 Inhibitoren: Atezolizumab, Avelumab, Durvalumab). Diese werden als Monotherapie oder in Kombination mit anderen Therapiemodalitäten wie Chemo- und Radiotherapie eingesetzt. Indikationen sind vor allem Erst- und Zweitlinientherapien bei soliden Tumoren in einem fortgeschrittenen Stadium. In klinischen Studien werden ICI aktuell in adjuvanten und neoadjuvanten Therapiekonzepten evaluiert.
Bei rund 20% der Patienten ist mit einem Ansprechen auf eine ICI Therapie zu rechnen. Verschiedene tumorbasierte prädiktive Biomarker (u.a. PD-L1 Expression, Tumor-infiltrierende T-Lymphozyten und andere Immunzelltypen in der Tumormikroumgebung, Veränderungen im Tumorzellgenom wie Mikrosatelliten-Instabilität, Tumormutationslast, und bestimmte Mutationen) sind mit einem Ansprechen bzw. einer Resistenz auf PD-1/PD-L1 Inhibitoren assoziiert (2). Der nachfolgende Beitrag fokussiert auf die diagnostischen Aspekte des PD-L1 Status.
Grundlagen
PD-L1 bildet zusammen mit seinem Rezeptor PD-1 einen hemmenden Immuncheckpunkt. PD-1 wird vor allem auf der Oberfläche von aktivierten T-Lymphozyten exprimiert. Die Bindung der Liganden PD-L1 oder PD-L2 an den PD-1 Rezeptor hemmt die Aktivität des Lymphozyten. Neben Immunzellen der Tumormikroumgebung (u.a. Makrophagen) können auch die Tumorzellen selbst PD-L1 exprimieren und so die anti-tumorale Aktivität von T-Lymphozyten unterdrücken. Durch gegen PD-1 oder PD-L1 gerichtete Antikörper lässt sich die immuninhibitorische Wirkung des PD-1/PD-L1 Immuncheckpunkts aufheben.
Methodische Aspekte der PD-L1 Immunfärbung
Der PD-L1 Status eines Tumors wird mittels immunhistochemischer Expressionsanalyse des PD-L1 Proteins ermittelt (Abb. 1). In klinischen Studien wurden vor allem vier kommerzielle PD-L1 Testkits verwendet: PD-L1 IHC 28-8 pharmDx (28-8), PD-L1 IHC 22C3 pharmDx (22C3), Ventana PD-L1 SP142 (SP142), und Ventana PD-L1 SP263 (SP263). Bei diesen Testkits handelt es sich um geschlossene Reagenzien-Systeme, die nur auf den Geräteplattformen der entsprechenden Hersteller eingesetzt werden können. Die in den Testkits verwendeten Primärantikörper (22C3, 28-8, SP142, SP263) sind allerdings auch als Einzelreagenzien verfügbar, so dass Pathologie-Institute mit diesen auch sog. Labor-entwickelte Tests (LDT) etablieren können. Weitere, häufig deutlich kostengünstigere PD-L1 Primärantiköper (u.a. E1L3N) stehen zur Verfügung, die bisher jedoch nur in wenigen klinischen Studien evaluiert wurden. Technisch kann eine PD-L1 Immunfärbung an Gewebeproben und zytologischem Probenmaterial durchgeführt werden. Bei jedem Färbedurchgang sollte ein positives Kontrollgewebe (bevorzugt Tonsillengewebe) als On-slide-Kontrolle zur internen Qualitätskontrolle mitgeführt werden. Für die Auswertung muss das Probenmaterial eine ausreichende Anzahl von Tumorzellen und/oder Immunzellen enthalten.
Auswertung (Scoring) des PD-L1 Status
Für die Beurteilung der PD-L1 Status wurden verschiedene Scoring-Systeme entwickelt (Tab. 1). Alle Scoring-Systeme basieren auf der Bestimmung relativer (prozentualer) Anteile gefärbter Zellen, bezogen auf die gesamte Tumorzellpopulation oder die Tumorfläche. Je nach Auswertescore wird die PD-L1 Positivität von Tumorzellen und/oder Immunzellen beurteilt. Bei der Beurteilung wird das Färbemuster, aber nicht die Intensität einer positiven Färbung berücksichtigt. In der klinischen Diagnostik werden je nach Studien- und Zulassungslage sowie geplanter ICI Therapie ein oder mehrere PD-L1 Scores für einen Tumortyp bestimmt und berichtet. PD-L1 Scores müssen einzeln und unabhängig voneinander ermittelt werden, ein Umrechnen ist aufgrund der unterschiedlichen Score-Definitionen nicht möglich. Auch wenn es Versuche gibt, den PD-L1 Status eines Tumors mittels digitaler Bildanalyse zu ermitteln, erfolgt die Auswertung nach wie vor ausschliesslich durch einen geschulten Pathologen.
Tumor Proportion Score
Der Tumor Proportion Score (TPS) entspricht dem relativen (prozentualen) Anteil der Tumorzellen mit PD-L1 Positivität. Als PD-L1 positiv werden Tumorzellen mit einer kompletten oder inkompletten PD-L1 Färbung der Tumorzellmembran beurteilt, unabhängig von der Färbeintensität.
Combined Positive Score
Der Combined Positive Score (CPS) berücksichtigt die PD-L1 Expression von Tumorzellen und tumorassoziierten Immunzellen (Makrophagen, Lymphozyten, dendritische Zellen). Zur Ermittlung des CPS wird in mehreren Gesichtsfeldern (bei 200-facher Vergrösserung) die Zahl der positiven Tumorzellen und Immunzellen bestimmt. Bei Tumorzellen gilt eine membranäre Anfärbung unabhängig von der Intensität als positiv, bei Immunzellen nur eine zytoplasmatische Anfärbung. Die Summe der PD-L1 positiven Zellen wird durch die Anzahl der Tumorzellen in den Gesichtsfeldern dividiert und der Quotient mit 100 multipliziert. Es entsteht ein dimensionsloser Wert, der dem CPS entspricht.
Immune Cell Score
Beim Immune Cell (IC)-Score wird der von PD-L1 positiven Immunzellen eingenommene Flächenanteil (intra- und unmittelbar peritumoral) in Beziehung zum gesamten Tumorareal beurteilt. Zum Tumorareal zählen die Tumorzellverbände selbst sowie das intratumorale und das unmittelbar peritumorale Stroma. Auszuwertende Immunzellen sind Lymphozyten, Makrophagen, dendritische Zellen und Granulozyten. Plasmazellen werden nicht berücksichtigt. Der PD-L1 positive Flächenanteil wird in 4 Score-Kategorien angegeben: IC 0: <1%, IC 1: >1 bis <5%, IC 2: > 5 bis < 10% und IC3 > 10%.
Inter-Assay-Variation der PD-L1 Testergebnisse
In zahlreichen Studien wurden kommerzielle PD-L1 Tests untereinander und mit LDT verglichen (3, 4). Als Beispiel sei die Blueprint-Studie genannt, in der NSCLC mit fünf verschiedenen kommerziellen PD-L1 Testkits (22C3, 28-8, SP142, SP263, 73-10) gefärbt und das Färbeergebnis mittels TPS und IC-Scoring verglichen wurden (5, 6). Für die PD-L1 Expression auf Tumorzellen ergab sich eine hohe Konkordanz der Testergebnisse, falls die Klone 28-8, 22C3, SP263 und 73-10 als Primärantikörper verwendet wurden. Hingegen war die Konkordanz deutlich geringer für die PD-L1 Expression auf Immunzellen. Eine kürzlich veröffentlichte Metaanalyse kommt zu der Schlussfolgerung, dass LDT und kommerzielle Testkits vergleichbare Ergebnisse liefern können, falls die Validierung des LDT mit geeigneten Referenzmaterialien erfolgt (4).
Qualitätssicherung
Wichtige qualitätssichernde Verfahren für die PD-L1 Testung sind die Standardisierung der Präanalytik, die Validierung von Färbeprotokollen, und die Verwendung von On-slide Kontrollen (Tonsillengewebe) zur internen Qualitätskontrolle. Besondere Bedeutung kommt der Teilnahme an Ringversuchen zur externen Qualitätssicherung zu. Die Beurteilung des PD-L1 Status unterliegt einer gewissen Interobserver-Variabilität (3). Gezielte Schulungen fördern die einheitliche Anwendung der verschiedenen Scoring-Systeme unter Berücksichtigung von tumortypspezifischen Besonderheiten.
Regulatorische Bedeutung des PD-L1 Status
Bei vielen Tumortypen besteht eine Korrelation zwischen PD-L1 Status und Ansprechen auf ICI. Aus regulatorischer Sicht ist eine PD-L1 Testung jedoch nur für einen Teil der in der Schweiz zugelassenen ICI in ausgewählten Indikationen erforderlich. Während Nivolumab, Durvalumab, Avelumab und Cemiplimab in den zugelassenen Indikationen unabhängig vom PD-L1 Status eingesetzt werden können, ist die Verwendung von Pembrolizumab (bei nicht-kleinzelligem Lungenkarzinom (NSCLC) und bei Kopf-Hals-Karzinom (HNSCC)) und von Atezolizumab (bei NSCLC und triple-negativem Mammakarzinom) an ein bestimmtes PD-L1 Testergebnis gebunden (Tab. 2). Die für die jeweilige Indikation genannten PD-L1 Schwellenwerte wurden in Zulassungsstudien ermittelt und klinisch validiert (7-13).
Herausforderungen in der klinischen Routinediagnostik
Tumoren zeigen häufig eine heterogene PD-L1 Expression. Am besten ist diese bei NSCLC dokumentiert (14, 15). Aufgrund der intratumoralen Heterogenität ist die Repräsentativität des für die PD-L1 Testung verwendeten Probenmaterials besonders wichtig. Weiterhin ist die PD-L1 Expression eines Tumors vermutlich dynamisch und kann sich im Krankheitsverlauf sowie durch Therapieeffekte ändern.
Bei den in klinischen Studien verwendeten PD-L1 Tests handelt es mehrheitlich um geschlossene Testkits. Diese können nur auf der Immunfärbeplattform des jeweiligen Testlieferanten eingesetzt werden. Da Pathologie-Institute in der Regel nur ein oder zwei Geräteplattformen verwenden, ist ein Vorhalten aller verfügbaren PD-L1 Tests aus betriebsorganisatorischen und wirtschaftlichen Gründen nicht möglich.
Schlussfolgerungen
Bei verschiedenen onkologischen Erkrankungen haben sich Inhibitoren des PD-1/PD-L1 Immuncheckpunks als Therapieoption etabliert. Trotz vieler mit der Testung und Auswertung verbundenen Herausforderungen ist der Tumor PD-L1 Status aktuell der am häufigsten verwendete und am besten klinisch validierte Biomarker, um ein Ansprechen auf PD-1/PD-L1 ICI vorherzusagen.
Copyright bei Aerzteverlag medinfo AG
Institut für Pathologie
Kantonsspital St. Gallen
9007 St. Gallen
Institut für Pathologie
Kantonsspital St. Gallen
9007 St. Gallen
wolfram.jochum@kssg.ch
Die Autoren haben in direktem Zusammenhang mit diesem Artikel keine Interessenkonflikte deklariert. WJ hat für Beratertätigkeit Honorare von MSD und Roche erhalten und von Roche und Astra Zeneca Unterstützung für Fortbildungen und Kongresse.
- Der PD-L1 Status eines Tumors beschreibt die PD-L1 Proteinexpression der Tumorzellen und/oder der Immunzellen des Tumorstromas.
- Die Analyse des PD-L1 Status erfolgt mittels Immunhistochemie. Zur Auswertung werden verschiedene Scoring-Systeme (TPS, CPS, IC Score) verwendet.
- Ein positiver PD-L1 Status ist bei verschiedenen Tumortypen mit einem Ansprechen auf PD-1/PD-L1 Immuncheckpunkt-Inhibitoren assoziiert.
- Die Verwendung von PD-1/PD-L1 Immuncheckpunkt-Inhibitoren ist in bestimmten Indikationen an einen positiven PD-L1 Status gebunden.
1. Vaddepally, R.K., Kharel, P., Pandey, R., Garje, R., and Chandra, A.B. (2020). Review of Indications of FDA-Approved Immune Checkpoint Inhibitors per NCCN Guidelines with the Level of Evidence. Cancers (Basel) 12, 738.
2. Havel, J.J., Chowell, D., and Chan, T.A. (2019). The evolving landscape of biomarkers for checkpoint inhibitor immunotherapy. Nat Rev Cancer 19, 133-150.
3. Buttner, R., Gosney, J.R., Skov, B.G., Adam, J., Motoi, N., Bloom, K.J., Dietel, M., Longshore, J.W., Lopez-Rios, F., Penault-Llorca, F., et al. (2017). Programmed Death-Ligand 1 Immunohistochemistry Testing: A Review of Analytical Assays and Clinical Implementation in Non-Small-Cell Lung Cancer. J Clin Oncol 35, 3867-3876.
4. Torlakovic, E., Lim, H.J., Adam, J., Barnes, P., Bigras, G., Chan, A.W.H., Cheung, C.C., Chung, J.H., Couture, C., Fiset, P.O., et al. (2020). “Interchangeability” of PD-L1 immunohistochemistry assays: a meta-analysis of diagnostic accuracy. Mod Pathol 33, 4-17.
5. Hirsch, F.R., McElhinny, A., Stanforth, D., Ranger-Moore, J., Jansson, M., Kulangara, K., Richardson, W., Towne, P., Hanks, D., Vennapusa, B., et al. (2017). PD-L1 Immunohistochemistry Assays for Lung Cancer: Results from Phase 1 of the Blueprint PD-L1 IHC Assay Comparison Project. J Thorac Oncol 12, 208-222.
6. Tsao, M.S., Kerr, K.M., Kockx, M., Beasley, M.B., Borczuk, A.C., Botling, J., Bubendorf, L., Chirieac, L., Chen, G., Chou, T.Y., et al. (2018). PD-L1 Immunohistochemistry Comparability Study in Real-Life Clinical Samples: Results of Blueprint Phase 2 Project. J Thorac Oncol 13, 1302-1311.
7. Reck, M., Rodriguez-Abreu, D., Robinson, A.G., Hui, R., Csoszi, T., Fulop, A., Gottfried, M., Peled, N., Tafreshi, A., Cuffe, S., et al. (2016). Pembrolizumab versus Chemotherapy for PD-L1-Positive Non-Small-Cell Lung Cancer. N Engl J Med 375, 1823-1833.
8. Reck, M., Rodriguez-Abreu, D., Robinson, A.G., Hui, R., Csoszi, T., Fulop, A., Gottfried, M., Peled, N., Tafreshi, A., Cuffe, S., et al. (2019). Updated Analysis of KEYNOTE-024: Pembrolizumab Versus Platinum-Based Chemotherapy for Advanced Non-Small-Cell Lung Cancer With PD-L1 Tumor Proportion Score of 50% or Greater. J Clin Oncol 37, 537-546.
9. Herbst, R.S., Baas, P., Kim, D.W., Felip, E., Perez-Gracia, J.L., Han, J.Y., Molina, J., Kim, J.H., Arvis, C.D., Ahn, M.J., et al. (2016). Pembrolizumab versus docetaxel for previously treated, PD-L1-positive, advanced non-small-cell lung cancer (KEYNOTE-010): a randomised controlled trial. Lancet 387, 1540-1550.
10. Herbst, R.S., Garon, E.B., Kim, D.W., Cho, B.C., Perez-Gracia, J.L., Han, J.Y., Arvis, C.D., Majem, M., Forster, M.D., Monnet, I., et al. (2020). Long-Term Outcomes and Retreatment Among Patients With Previously Treated, Programmed Death-Ligand 1Positive, Advanced NonSmall-Cell Lung Cancer in the KEYNOTE-010 Study. J Clin Oncol 38, 1580-1590.
11. Cohen, E.E.W., Soulieres, D., Le Tourneau, C., Dinis, J., Licitra, L., Ahn, M.J., Soria, A., Machiels, J.P., Mach, N., Mehra, R., et al. (2019). Pembrolizumab versus methotrexate, docetaxel, or cetuximab for recurrent or metastatic head-and-neck squamous cell carcinoma (KEYNOTE-040): a randomised, open-label, phase 3 study. Lancet 393, 156-167.
12. Burtness, B., Harrington, K.J., Greil, R., Soulieres, D., Tahara, M., de Castro, G., Jr., Psyrri, A., Baste, N., Neupane, P., Bratland, A., et al. (2019). Pembrolizumab alone or with chemotherapy versus cetuximab with chemotherapy for recurrent or metastatic squamous cell carcinoma of the head and neck (KEYNOTE-048): a randomised, open-label, phase 3 study. Lancet 394, 1915-1928.
13. Schmid, P., Adams, S., Rugo, H.S., Schneeweiss, A., Barrios, C.H., Iwata, H., Dieras, V., Hegg, R., Im, S.A., Shaw Wright, G., et al. (2018). Atezolizumab and Nab-Paclitaxel in Advanced Triple-Negative Breast Cancer. N Engl J Med 379, 2108-2121.
14. Munari, E., Zamboni, G., Lunardi, G., Marchionni, L., Marconi, M., Sommaggio, M., Brunelli, M., Martignoni, G., Netto, G.J., Hoque, M.O., et al. (2018). PD-L1 Expression Heterogeneity in Non-Small Cell Lung Cancer: Defining Criteria for Harmonization between Biopsy Specimens and Whole Sections. J Thorac Oncol 13, 1113-1120.
15. McLaughlin, J., Han, G., Schalper, K.A., Carvajal-Hausdorf, D., Pelekanou, V., Rehman, J., Velcheti, V., Herbst, R., LoRusso, P., and Rimm, D.L. (2016). Quantitative Assessment of the Heterogeneity of PD-L1 Expression in Non-Small-Cell Lung Cancer. JAMA Oncol 2, 46-54.
der informierte @rzt
- Vol. 10
- Ausgabe 12
- Dezember 2020